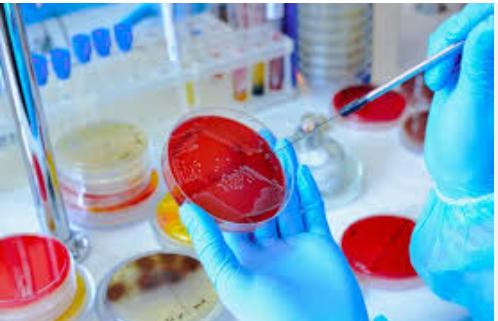
Textile Testing

Why Bai-Labs?
NABL-Accredited Lab - thus meeting international standards (ISO/IEC 17025) for testing.
Recognized by ILAC (International Laboratory Accreditation Cooperation)- our test results are accepted globally
Advanced Testing Facilities- for microbiology, chemical, nutritional value,shelf-life testing and adulteration analysis.
Quick Turnaround Time - to meet your production and compliance deadlines
Expert Technical Team- comprising food technologists, chemists, and microbiologists to ensure accurate results.
Transparent & Ethical Practices – Honest reporting and a commitment to quality.